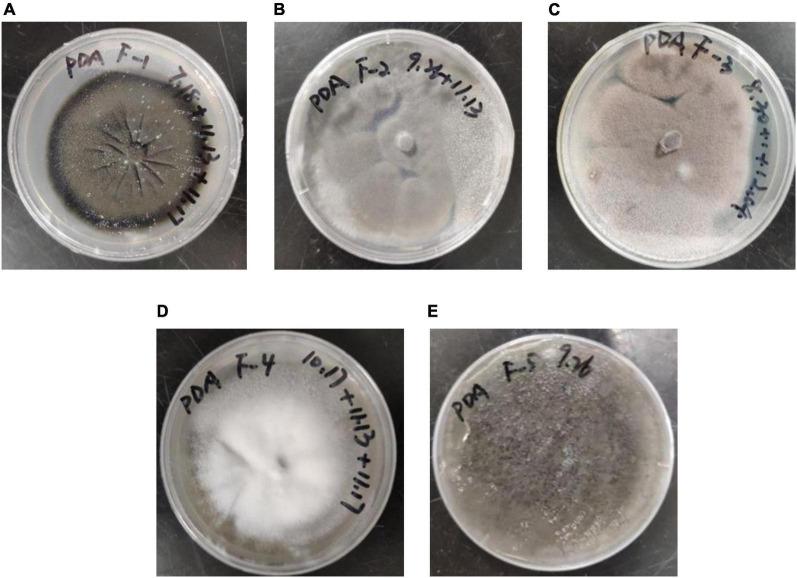
https://cdn.ncbi.nlm.nih.gov/pmc/blobs/296e/10999689/2ad9daeada60/fmicb-15-1371877-g001.jpg

用于电解质中重金属吸附的真菌筛选及性能优化
Screening and performance optimization of fungi for heavy metal adsorption in electrolytes.
作者信息
Yang Yuhui, Liu Rui, Zhou Yizhou, Tang Yingnan, Zhang Jing, Wang Yu, Dai Tingting, Zou Ping, Bi Xiaoyi, Li Shuibing
机构信息
Institute of International Rivers and Eco-Security, Yunnan University, Kunming, China.
School of Ecology and Environmental Science, Institute for Ecological Research and Pollution Control of Plateau Lakes, Yunnan University, Kunming, China.
出版信息
Front Microbiol. 2024 Mar 25;15:1371877. doi: 10.3389/fmicb.2024.1371877. eCollection 2024.
The resource recovery and reuse of precious metal-laden wastewater is widely recognized as crucial for sustainable development. Superalloy electrolytes, produced through the electrolysis of superalloy scrap, contain significant quantities of precious metal ions, thereby possessing substantial potential for recovery value. This study first explores the feasibility of utilizing fungi to treat Superalloy electrolytes. Five fungi resistant to high concentrations of heavy metals in electrolytes (mainly containing Co, Cr, Mo, Re, and Ni) were screened from the soil of a mining area to evaluate their adsorption characteristics. All five fungi were identified by ITS sequencing, and among them, showed the best adsorption performance for the five heavy metals; therefore, we conducted further research on its adsorption characteristics. The best adsorption effect of Co, Cr, Mo, Re, and Ni was 37.09, 64.41, 47.87, 41.59, and 25.38%, respectively, under the conditions of pH 5, time 1 h, dosage 26.67 g/L, temperature 25-30°C, and an initial metal concentration that was diluted fivefold in the electrolyte. The biosorption of Co, Mo, Re, and Ni was better matched by the Langmuir model than by the Freundlich model, while Cr displayed the opposite pattern, showing that the adsorption process of for the five heavy metals is not a single adsorption mechanism, but may involve a multi-step adsorption process. The kinetics study showed that the quasi-second-order model fitted better than the quasi-first-order model, indicating that chemical adsorption was the main adsorption process of the five heavy metals in . Fourier transform infrared spectroscopy revealed that the relevant active groups, i.e., hydroxyl (-OH), amino (-NH), amide (- CONH), carbonyl (-C = O), carboxyl (-COOH), and phosphate (PO), participated in the adsorption process. This study emphasized the potential application of in the treatment of industrial wastewater with extremely complex background values.
含贵金属废水的资源回收与再利用被广泛认为对可持续发展至关重要。通过超合金废料电解生产的超合金电解液含有大量贵金属离子,因此具有巨大的回收价值潜力。本研究首先探讨利用真菌处理超合金电解液的可行性。从某矿区土壤中筛选出五种对电解液中高浓度重金属(主要含Co、Cr、Mo、Re和Ni)具有抗性的真菌,以评估它们的吸附特性。通过ITS测序对这五种真菌进行了鉴定,其中, 对五种重金属表现出最佳吸附性能;因此,我们对其吸附特性进行了进一步研究。在pH值为5、时间为1小时、用量为26.67 g/L、温度为25 - 30°C以及电解液中初始金属浓度稀释五倍的条件下,Co、Cr、Mo、Re和Ni的最佳吸附效果分别为37.09%、64.41%、47.87%、41.59%和25.38%。Co、Mo、Re和Ni的生物吸附与Langmuir模型的匹配度优于Freundlich模型,而Cr则呈现相反模式,表明 对五种重金属的吸附过程不是单一的吸附机制,而是可能涉及多步吸附过程。动力学研究表明,准二级模型比准一级模型拟合得更好,这表明化学吸附是 中五种重金属的主要吸附过程。傅里叶变换红外光谱显示,相关活性基团,即羟基(-OH)、氨基(-NH)、酰胺(-CONH)、羰基(-C = O)、羧基(-COOH)和磷酸根(PO)参与了吸附过程。本研究强调了 在处理背景值极其复杂的工业废水中的潜在应用。